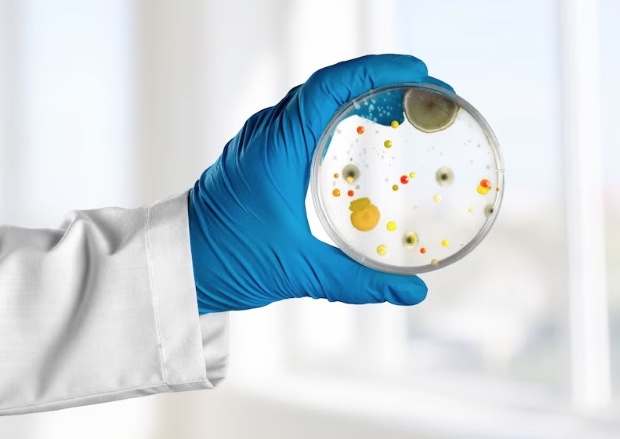
Infecções bacterianas são a segunda principal causa de morte no mundo

As infecções bacterianas ocupam o segundo lugar no ranking das doenças que mais matam no mundo, de acordo com um estudo publicado no periódico científico The Lancet[ii] no ano passado, ficando atrás apenas das doenças do coração.
O levantamento mostra que a resistência aos antibióticos esteve associada a quase 5 milhões de mortes, e foi diretamente responsável por cerca de 1,27 milhão de óbitos em 2019 (período do levantamento)2.
“As infecções por bactérias resistentes , ou seja, aquelas que precisam de antibióticos mais potentes devido ao uso descontrolado e sem acompanhamento médico dos antibióticos, já são um problema de saúde pública e precisamos desenvolver ações que ajudem a reduzir o número de casos dentro e fora dos hospitais”, explica Ricardo Kosop, coordenador do projeto Antimicrobial Stewardship no Hospital Angelina Caron (HAC) – referência em atendimentos de alta complexidade, localizado na Região Metropolitana de Curitiba.
De acordo com o médico, a higienização das mãos é considerada uma estratégia de prevenção de infecções com maior e mais robusta evidência de efetividade, além do baixíssimo custo e relativa simplicidade. Contudo, embora simples, e mesmo após tudo o que vivemos durante a pandemia, ainda costuma ser ignorada no dia a dia, tanto por pessoas comuns como por profissionais de saúde.
Segundo a Organização Mundial da Saúde (OMS), lavar as mãos sempre que necessário ajuda a reduzir em aproximadamente 40% doenças como gripe, conjuntivite e viroses[iii].
Com informações da assessoria

Aviso